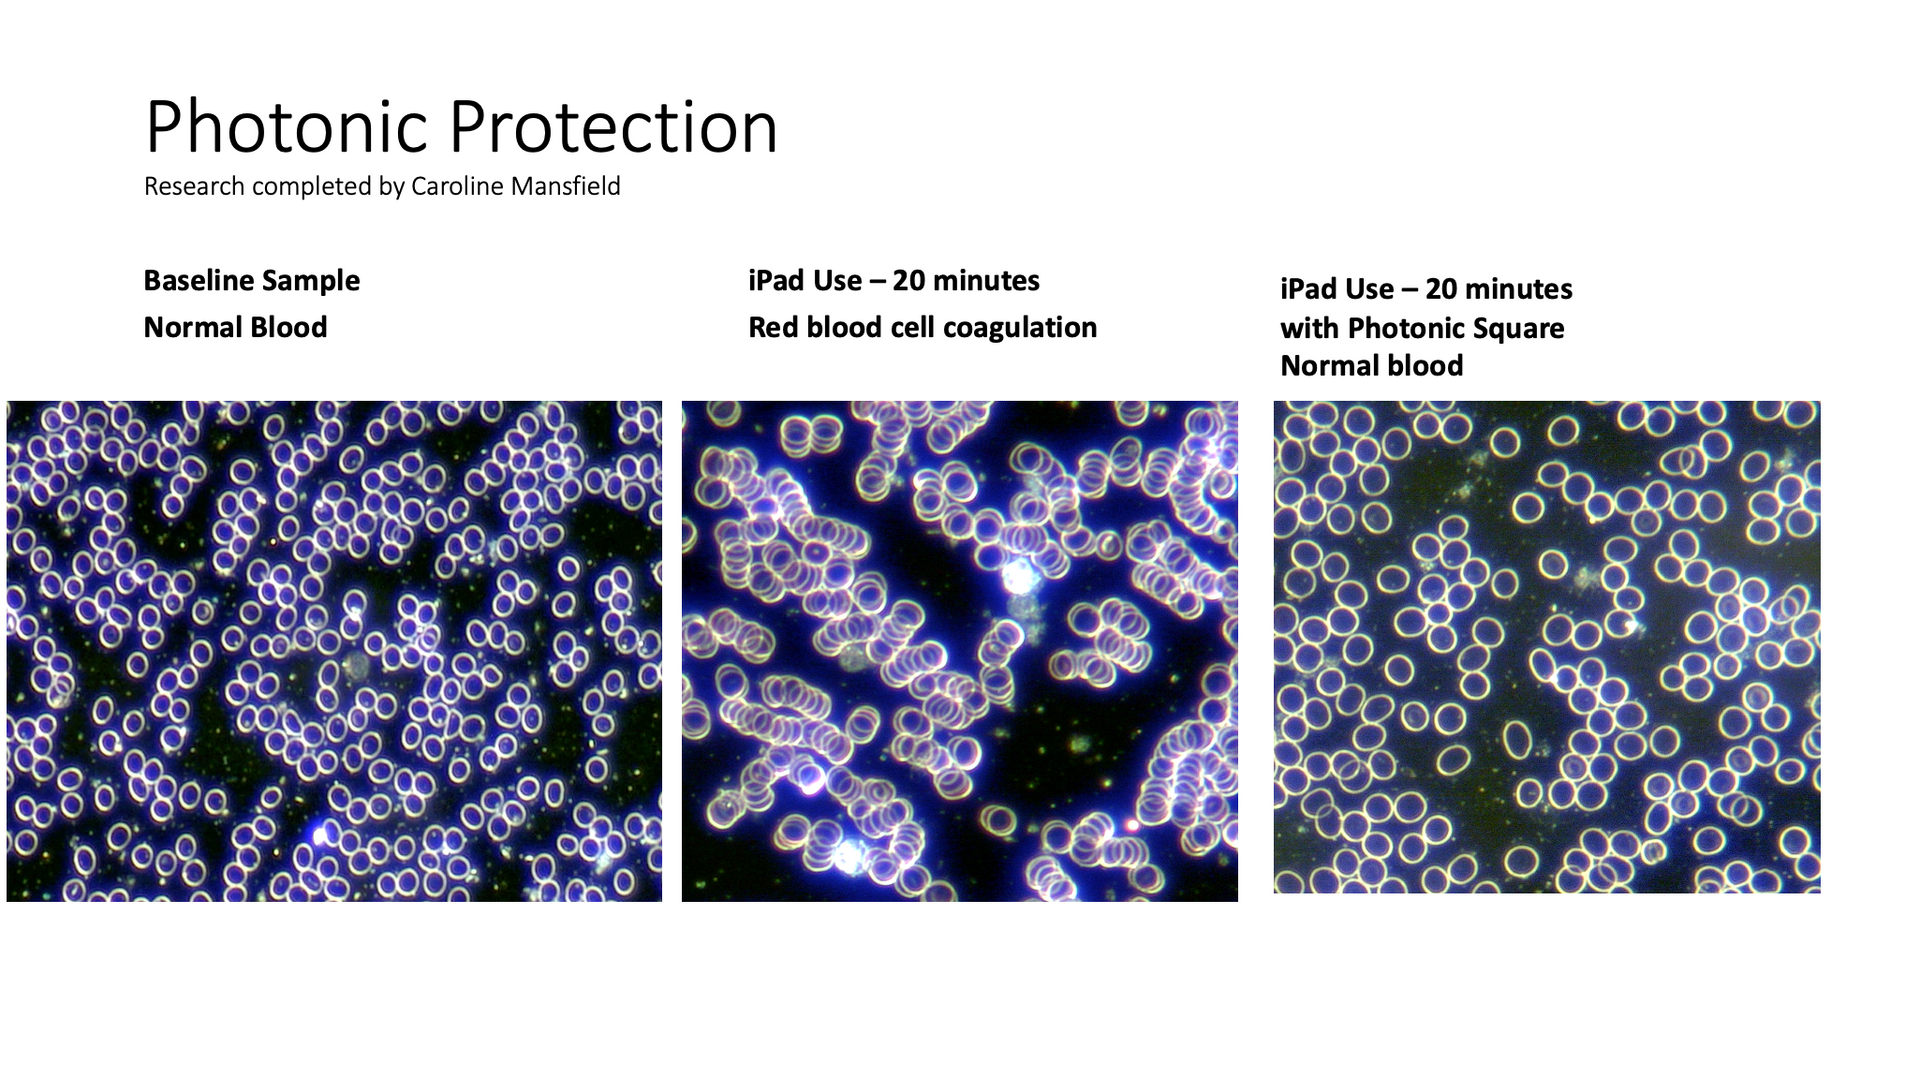

DETOX | NUTRITION | LIFESTYLE
Photonic EMF Protection
Thanks to Photonic's technology, unique design and mix of science and nature, as certified by the Bion Institute, Photonic Wave and Photonic Cards protect you from the negative effects of 5G, 6G, EMR, Geopathic Zones at home and on the go through airports, business premises, shops, street lamps and cell towers etc. 10% Discount on all purchases use code CM10 click here